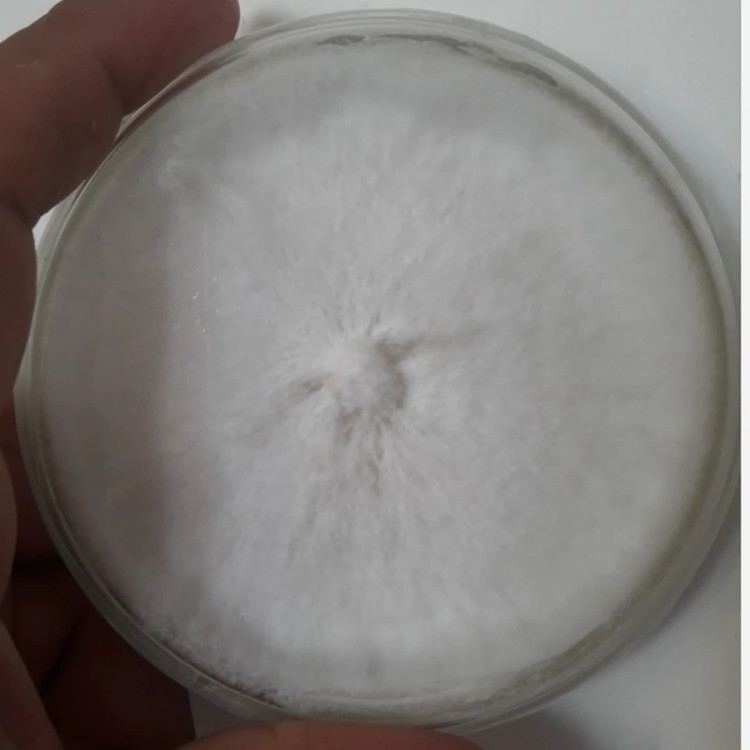

دستهبندی: بذر سبزیجات

پلیت قارچ انوکی سفید
توضیحات
تهیهشده از سویه خالصسازیشده و رشدیافته در محیط کاملاً استریل، آماده عرضه است. این پلیت پس از انجام تستهای کنترل آلودگی (QC)، بررسی یکنواختی رشد در محیط PDA و تأیید پایداری سویه، مناسب تولید اسپان میباشد. میسلیوم فعال، رشد یکنواخت و قدرت کولونیزاسیون بالا، کیفیت این پلیت را برای تکثیر حرفهای تضمین میکند. تمامی مراحل تهیه، انکوباسیون و نگهداری تحت شرایط آزمایشگاهی انجام شده و سلامت و خلوص کشت تضمین میگردد
نظرات
دستهبندی: بذر سبزیجات